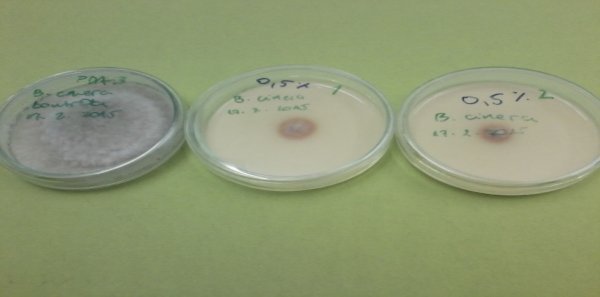

Iako je stoljećima poznat kao ljekovit proizvod koji pridonosi imunitetu i općenito zdravlju, odnosno ublažava simptome određenih bolesti kod ljudi i životinja, posebice pčela koje ga i proizvode iz biljnih smola, propolis se u novije vrijeme sve više koristi i u poljoprivredi, i to za suzbijanje nekih gljivičnih bolesti. Praksa je to, doduše, prije svega ekoloških voćara i vinogradara pojedinih zapadnoeuropskih zemalja, dok se u nas zasada provode samo istraživanja koja potvrđuju njegovu učinkovitost u suzbijanju bolesti biljaka, što je osobito bitno kod ekološke poljoprivredne proizvodnje u kojoj se vidi budućnost jer njeni proizvodi ne sadrže ostatke konvencionalnih sredstava zaštite koji mogu narušiti ljudsko zdravlje
O mogućnostima upotrebe propolisa u zaštiti bilja prva istraživanja u nas su proveli stručnjaci Zavoda za ribarstvo, pčelarstvo, lovstvo i specijalnu zoologiju Agronomskog fakulteta u Zagrebu potvrdivši da taj pčelinji proizvod ima antibakterijsko, antigljivično i insekticidno djelovanje te da potiče rast i razvoj biljaka. Protugljivično djelovanje propolisa nedavno su potvrdila i istraživanja Ane Kikić i Sanje Krajinović, apsolventica ekološke poljoprivrede na osječkom Poljoprivrednom fakultetu. Dok je Kikić istraživala utjecaj različitih koncentracija alkoholne otopine propolisa na gljive (Botrytis cinerea i Sclerotinia sclerotiorum), tj. parazite koji izazivaju sivu plijesan, odnosno trulež stabljike, vrata korijena, palež cvijeta i sl., Krajinović je u svom diplomskom radu istraživala utjecaj propolisa na porast Pythium irregulare i Fusarium solani, fitopatogenih gljiva koje napadaju velik broj biljaka iz različitih porodica te izazivaju različite tipove bolesti, kao što supalež klijanaca kod pšenice, ječma i kukuruza, zatim trulež korijena kod istih kultura, pa trulež stabljike kukuruza i palež klasova pšenice...
Fitopatogene gljive mogu uzrokovati ozbiljne ekonomske štete. Gljivične bolesti uzrokuju gubitke na usjevima na oko 12 posto svjetske proizvodnje. Zbog visoke razine genetskih varijacija fitopatogenih gljiva pojava gubitka djelotvornosti kemijskih fungicida na gljivične patogene rezultira rezistentnošću na fungicide. Stoga se upotreba prirodnih proizvoda poput propolisa za kontrolu gljivičnih bolesti biljaka smatra obećavajućom alternativom sintetičkim fungicidima te ima manje negativan utjecaj na okoliš', ističe Krajinović pozivajući se na istraživanja nekoliko autora.
Posebno ukazuje na to da su flavonoidi, benzojeva kiselina i derivati pronađeni u propolisu pokazali antibiotski, antivirusni i antifungalni učinak, pa se preparati na bazi propolisa sve više koriste za suzbijanje, primjerice, štitastih ušiju i plijesni plodova agruma, zatim protiv maslinove muhe i raka, kovrčavosti breskve, peronospore i sive plijesni vinove loze...
'U okviru našeg studija poljoprivrede imamo smjer ekološka poljoprivreda i na tom smjeru govorimo o ekološkoj zaštiti bilja od uzročnika bolesti, prihvatljivoj u takvom sustavu proizvodnje. Dosad smo ispitivali djelovanje različitih eteričnih ulja, pa ekstrakta aloa vere, a na tu temu objavili smo i rad. Sada su, u okviru svog diplomskog rada, studentice u laboratoriju ispitivale utjecaj proplisa na patogene gljive, odnosno uzročnika bijele truleži.Djelotvornost propolisa je bila vrlo zadovoljavajuća u laboratorijskim uvjetima', veli mentorica studentica, izvanredna profesorica Karolina Vrandečić, koja se na Poljoprivrednom fakultetu u Osijeku bavi fitopatologijom, tj. uzročnicima bolesti biljaka.
U svijetu, kako dodaje, dosta je sličnih istraživanja u laboratorijima, ali i u realnom okruženju, tj. na konkretnoj proizvodnji.
'Pronašli smo, primjerice, istraživanje utjecaja propolisa koje je obavljeno u Čileu. Iako ima i drugih, mi smo istraživanja nekih gljiva proveli prvi put, koliko nam je poznato. Stoga sam potaknula studentice da svoja istraživanja objave kao znanstveni rad i nadam se da će se to uskoro dogoditi', naglašava dr. Vrandečić te najavljuje daljnja, slična istraživanja.
Ispitati djelovanje propolisa na poljima
Budući da se u laboratoriju pokazalo da propolis ima jako dobro antifungalno i antiseptičko djelovanje na gljive koje su bile predmet istraživanja, drži da bi bilo jako dobro ispitati to i na pokusnim poljima.
'Nažalost, malo toga izlazi iz laboratorija. Kolegice koje su radile pokuse nisu imale svoje parcele. Proveli bismo više takvih istraživanja, ali smo ograničeni kao fakultet. Znanstveno-nastavna smo ustanova i imamo dosta sati nastave, a kako radim bez asistenta, jako je teško odvojiti vrijeme za ekološka istraživanja, iako bih to voljela jer ima uistinu poticajnih i zanimljivih rezultata. Primjerice, imali smo fantastično istraživanje djelovanja ekstrakta koji daju gliste na jednu patogenu gljivu što uzrokuje plamenjaču krumpira. Bila bih presretna da mogu zadržati tu studenticu koja je izuzetan potencijal, ali situacija je takva kakva je', veli profesorica osječkog Poljoprivrednog fakulteta koja bi voljela ponoviti pokuse i u vanjskim uvjetima, i to u suradnji s proizvođačima.
Bez istraživanja u realnim uvjetima, kako upozorava profesorica, također članica Hrvatskog društva biljne zaštite, teško je očekivati značajniju upotrebu ekoloških sredstava.
'Vidimo gotovo iz dana u dan da je na tržištu dopušten sve manji broj aktivnih tvari i klasičnih sredstava zaštite, tj. pesticida. Svijest o ekološkom načinu proizvodnje doista se širi i Europa definitivno ide u pravcu što manje upotrebe sredstava za zaštitu bilja i svi mi imamo takvu želju. Nastojimo što više zagovarati ekološki pristup i educirati u tom pravcu kako bi se smanjila upotreba konvencionalnih sredstava zaštite. I ja sam tome sklona, ali nedostaje znanstvenih istraživanja na tom području. Postoje doduše amaterska istraživanja u kojima pojedinci isprobavaju nešto. Međutim, ako doista želimo dobiti povjerenje velikih proizvođača, onda moramo provesti istraživanja u konkretnim uvjetima. Veliki proizvođači ne žele riskirati, žele dokazanu djelotvornost', ukazuje profesorica, dodajući da su tretmani propolisom skuplji od konvencionalnih, što je u ovom trenutku ozbiljna prepreka njegovoj primjeni u nas.
Komplicirana i skupa registracija preparata za ekološku poljoprivredu
Da za ekološku poljoprivredu uistinu nemamo sve potrebne uvjete, izuzev zemlje, govori upravo nedostatak ekoloških sredstava za zaštitu kojih je sve više u svijetu.Mikorizne preparate priprema 25 zemalja, a od svih bioefektora oko polovice su biognojiva, kod kojih nema troškova registracije. U Europi slijede biostimulatori, a najmanje je bioprotektanata, čija registracija traje od 10 do 15 godina te stoji oko 15 milijuna eura.
'Koliko je meni poznato, na našem tržištu, nažalost, trenutno nemamo niti jedno registrirano ekološko sredstvo za zaštitu biljaka od uzročnika bolesti. Donedavno ju je imalo jedno sredstvo, ali ga je izgubilo, dok je drugo u postupku registracije. Registracija ekoloških sredstava je jako skup i dugotrajan proces, tako da se na tržište radije plasiraju biostimulatori kod kojih ne treba takav postupak, pa ga proizvođači izabiru kao lakši put. Oni pomažu kod rasta i razvoja biljaka te posredno djeluju na povećanu tolerantnost prema bolestima, a nisu registrirani kao sredstava za zaštitu bilja. Za potonje, kao što sam već naglasila, treba i novac i vrijeme, odnosno ozbiljna istraživanja. Dok njih nema, ne možemo napraviti nagli iskorak ili prijelaz iz konvencionalne poljoprivrede, već moramo ići korak po korak, tim više što za ekološku proizvodnju treba jako puno znanja, a naši ga proizvođači trenutno nemaju', drži profesorica, ističući da ekološka poljoprivreda nije povratak na poljoprivredu naših predaka, već je dio suvremene poljoprivredne proizvodnje koja se temelji na najnovijim spoznajama i dostignućima, kao što je na to upozorio dr. Darko Znaor.